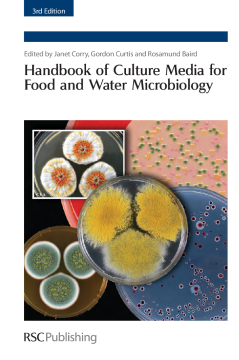
Handbook of Culture Media for Food and Water Microbiology Handbook of Culture Media for Food and Water Microbiology

BOOK
Handbook of Culture Media for Food and Water Microbiology
Basil Jarvis | Gerard Weenk | Peter J Stephens | B M Mackey | Matthias Fischer | Sha Zhu | Ellen de Ree | D Fritze | R Puckall | R R Beumer | Peter Zangerl | H Becker | G Klein | U Schillinger | W H Holzapfel | Rick Holley | Catherine Stanton | R P Ross | E Vihavainen | J Bjorkroth | M Aminul Islam | E De Boer | A E Heuvelink | Carol Iversen | Patrick Druggan | J D Oliver | H I Atabay | I Perales | Celia J Hugo | P J Jooste | Larry R. Beuchat | Tibor Deak | Simon in't Veld | H Veenendaal | J Watkins | David Sartory | Mohammad Manafi Manafi | Kristen Mooijman | Janet E L Corry | Gordon D W Curtis | R M Baird | Martin Adams | Maurice O Moss | Iain Ogden
(2011)
Additional Information
Book Details
Abstract
This is the highly anticipated third edition of a book written by the Working Party on Culture Media of the International Committee on Food Microbiology and Hygiene. It is a handy reference for microbiologists wanting to know which media to use for the detection of various groups of microbes in foods and how to check the performance of the media. The book is divided into two parts and concentrates on media for water as well as food microbes - selecting those which have been evaluated and shown to function optimally. The first part consists of a series of chapters written by various experts from all over the world, reviewing the media designed to detect the major groups of microbes important in food spoilage, food fermentations and food-borne disease. The history and rationale of the selective agents and indicator systems used, as well as the relative merits of the various media are surveyed by reference to the scientific literature. The second part contains monographs on almost 100 of the media considered most useful. Each monograph, written in the style of a pharmacopoeia, includes: a short section on the history and selective principle of the medium; a method for its preparation from basic ingredients; its appearance and physical properties, including pH; its shelf-life; instructions concerning method of inoculation, incubation and interpretation; the recommended method(s) and a list of test strains suitable for assessing the quality (productivity and selectivity) of the medium and a description of the typical appearance of the target organism.
Dr Janet Corry is currently Reader in Food Microbiology at the University of Bristol, Department of Clinical Veterinary Science. She has worked as an Assistant Experimental Officer for the ARC (Agricultural Research Council) Food Research Institute, Norwich and the ARC Meat Research Institute, Langford, Bristol. After that she became a Senior Scientist at the Leatherhead Food Research Association and then Senior Scientific Officer at the Metropolitan Police Forensic Science Laboratory, London. After that she was Senior Scientific Officer/Principal Scientific Officer in the UK Ministry of Agriculture, Fisheries and Food (MAFF), Food Science Division, London. She was subsequently appointed as Senior Microbiologist for J. Sainsbury supermarket in charge of their food microbiology laboratory in London. She has edited numerous books, has lectured on WHO Food Microbiology courses at the University of Surrey and runs an intensive two-week microbiology module for the University of Bristol MSc in Meat Science and Technology. Gordon Curtis trained at the Royal Army Medical College in London and subsequently worked in various army laboratories, mostly in the Middle East. He then worked in hospital microbiology departments at Bristol, Bath and Oxford where, for many years, he was in charge of the media preparation department at the Radcliffe Infirmary and the John Radcliffe Hospital. A former Fellow of the Institute of Biomedical Sciences he is now retired and has held part time teaching appointments at the Oxford College of Further Education and the Oxford Polytechnic and is a member of the International Committee on Food Microbiology and Hygiene's Working Party on Culture Media (WPCM). He was appointed Convenor of the WPCM in 1990 and has served on CEN groups associated with culture media and their quality assessment for many years. He is a member of the Society for Applied Microbiology. Dr Rosamund Baird is currently Honorary Senior Lecturer in the Department of Pharmacy and Pharmacology at the University of Bath. After graduating with a Bachelor of Pharmacy and a Ph.D, she undertook a post-doctoral fellowship at Leiden University and was appointed Honorary Lecturer at St. Bartholomew's Hospital Medical College. She then worked as principal pharmacist and regional quality controller at St. Bartholomew's Hospital, London, specializing in pharmaceutical microbiology. She has published and lectured extensively in this area and has also edited a number of related publications on both pharmaceutical and food microbiology. As a consultant, she has provided specialist training on microbiological aspects of production, GMP, QA, auditing and validation to the pharmaceutical, cosmetic, medical device and herbal industries. She has served on a number of national and international committees, including those of the British Pharmacopoeia Commission and was awarded a Daphne Jackson Fellowship at the University of Bath in 1996. She is an honorary member of the Pharmaceutical Microbiology Interest Group and was elected Fellow of The Royal Pharmaceutical Society in 2004.